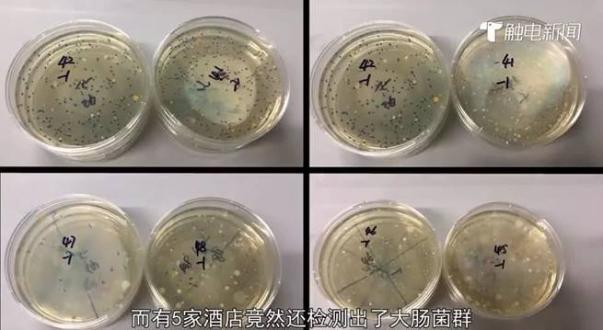
广州多家酒店查出细菌超标,连锁酒店有多脏

怎么躲开这些致病菌?
11月14日,微博用户“花总丢了金箍棒”发布视频,曝光高档酒店的卫生乱象。[1]

花总(图片来源:澎湃新闻)
高档酒店尚且如此,普通酒店又如何呢?近日,有记者对快捷酒店进行调查,结果显示,10家酒店里有4家细菌总数超标,有5家竟然检测出大肠杆菌、金黄色葡萄球菌。[2]
检测结果(图片来源:腾讯网)
这些细菌到底是何方妖孽,我们身边还有哪些特别常见的致病菌呢?
金黄色葡萄球菌:模样可爱,害人不浅
金黄色葡萄球菌,沾了好几个“最”字。
葡萄球菌属,长得都像葡萄,是自然界分布最广泛的细菌。土壤、水、空气中都可能有它们的身影。而金黄色葡萄球菌,像一串串金葡萄,是葡萄球菌属家族里最主要的致病菌,也是同辈中致病能力最强的。[3]

金黄色葡萄球菌(图片来源:livescience)
电影中,有时会出现处理伤口的场景,之所以用烧红的铁块烫伤口,提防的正是金黄色葡萄球菌。这群小家伙跟“渣男”差不多,广撒网,愿者上钩。正常人的皮肤、鼻咽部,偶尔也会沾染一些,不过没什么大碍;一旦皮肤破损或身体抵抗力下降,它们就会趁虚而入。一面大肆繁殖,一面释放各种有害物质。
这些有害物质,大致包括两类。一类是酶类。酶类可以形成血栓,阻挠免疫细胞,或者分解正常组织,方便细菌扩大、拓深战线。得过“火疖(jiē)子”的人知道,皮肤表面忽然长出疙瘩,比青春痘大,疼痛异常,如果不及时处理,顶部会变软、破溃,出现脓液。临床上称之为皮肤脓肿,罪魁祸首通常就是金黄色葡萄球菌。

皮肤脓肿(图片来源:prevention)
另一类有害物质是毒素,如肠毒素。肠毒素若吃进肚子,会“诱拐神经”,引起上吐下泻。
大肠杆菌:时好时坏的两面派
相比于金黄色葡萄球菌,大肠杆菌的名气无疑更大,身份也更加暧昧。

大肠杆菌(图片来源:维基)
据媒体报道,2015年,诺丁汉一家餐厅的大量顾客因大肠杆菌感染而患病。[4]巧合的是,当年的“引文桂冠奖”颁发给了华盛顿大学的Jeffrey I.Gordon教授[5]——他长期研究肠道菌群与健康的关系,而所有人的肠道里都有大肠杆菌。
大肠杆菌的学名叫大肠埃希菌(Escherichia coli),因为它是埃舍里奇(Theodor Escherich)无意中发现的。埃舍里奇当时在研究霍乱,霍乱最典型的表现是腹泻,他在霍乱患者的粪便中,找到了一种短棒状的细菌,即大肠杆菌。

埃舍里奇(图片来源:维基)
大肠杆菌属于机会致病菌。在肠道内,除了大肠杆菌之外,还有许多其他种类的细菌。它们之间会抢地盘、抢养分,彼此制衡。在那里,大肠杆菌像个乖孩子,制造维生素K,积极维持正常的凝血机制。[6]
一旦离开肠道环境,大肠杆菌就变得顽劣无比,会引起肠道外感染,比如阑尾炎等。还有一些特殊的大肠杆菌,它们即使进入肠道也不驯服,会破坏肠上皮细胞,引起肠功能异常,造成腹痛、腹泻等症状。
大肠杆菌每个人肚子里都有,连带着粪便内通常也会出现,所以,卫生人员常常用大肠杆菌的数目判断样品(食物、水源等)被粪便污染的程度,程度越深,出现其他致病菌的概率越大。
军团菌:中央空调的“亲密伙伴”
军团菌,确实与军团有关。
1976年,美国一群退伍军人在费城聚会。宴饮过后,多数人出现了严重的肺部感染,当时称之为军团病。后来,研究者从死亡患者的肺组织里分离出一种新细菌,这便是军团菌。[7]我国也出现过类似的病历。2000年,海军某部队在换防时,补给船上出现了大量疑似空调病的患者,进一步研究显示,罪魁祸首同样是军团菌。[8]

军团菌(图片来源:维基)
为什么军团菌总跟军人过不去?换句话说,餐厅和补给船,有什么共同之处呢?
答案是空调。餐厅、军舰上的空调,通常是中央空调,有冷却水塔。军团菌生活在水中,喜欢35℃左右的温度,但是抵抗力很强,即使在蒸馏水内,也可以存活一百天以上。因此,只要军团菌出现在中央空调的冷却水塔中,便有可能长期生存,伺机繁殖。2000年,有学者对北京14家四五星级的大饭店进行调查,结果显示,其中12家的空调冷却塔存在军团菌污染。[9]
军团菌主要侵袭呼吸道,引起军团病,临床上可出现发烧、肌肉酸痛等症状,严重时可出现多器官损害,危及生命。

军团病的主要表现(图片来源:CDC)
沙门杆菌:主动出击的致病菌
俗话说,百里不同俗。日本电视剧、电影里,常常出现生吃鸡蛋的情节。用生鸡蛋做蘸料,或者生鸡蛋拌饭之类。这种做法,国内观众最好不要效仿——因为鸡蛋可能会被沙门杆菌污染。

生蛋盖饭(图片来源于网络)
沙门杆菌,也称沙门氏菌(Salmonella),“杆”说的形态,“氏”指的是命名人。1885年,史密斯(Theobald Smith )第一次分离出了沙门氏菌,而后他的领导Daniel Elmer Salmon,用自己的名字命名了它。

沙门菌(图片来源:foodsafetynews)
和上述几个老伙计不同,沙门菌属门丁兴旺,现已发现2000多种血清型。其中,比较重要的有两类,一类是伤寒沙门菌,可以引起伤寒,患者常有发热、脾脏肿大等症状;另一类是肠炎沙门菌,它可以引起胃肠炎。如果食用了被其污染的食物,如肉类、鸡蛋等,便可能出现发热、呕吐、腹痛、腹泻等症状,一般2~3天自愈。
和其他细菌的另一个不同在于,沙门菌主要通过自身侵袭导致疾病,只有少数几种会分泌毒素。所以,沙门菌的致病力跟数量有明显关系。[3]
为了减少由这些常见细菌引起的疾病,国内颁布了诸多文件。如《公共场所卫生管理条例实施细则》规定,集中空调的通风系统要定期清洗消毒;《旅店业卫生标准》规定,茶具、毛巾、卧具,不得检出大肠菌群;食品的管理更严,《食品中致病菌限量》中要求,所有类型的食物中,沙门氏菌、大肠杆菌都不得检出。

《旅店业卫生标准》相关条文
当然,具体效果如何,还要看卫生监督部门的努力。
在日常生活中,金黄色葡萄球菌最好对付,保持皮肤清洁,万一出现伤口,立刻清创、避免感染;大肠杆菌和沙门氏菌都不耐热,只要把食物充分做熟,便能有效降低感染的概率;至于军团菌,普通人接触到的机会不多,不过,空调定时清洗,适当开窗通风, 永远不会错。
参考文献
[1] 大V花总的三次曝光:表、世奢会和酒店_七环视频_澎湃新闻[EB/OL]. [2018-12-09].
[2] 这些快捷酒店细菌超标!城市便捷、汉庭等酒店还检出致病菌!-腾讯新闻[EB/OL]. [2018-12-09].
[3] 李凡, 徐志凯. 医学微生物学[M]. 北京: 人民卫生出版社, 2013.
[4] 煎蛋网. 餐厅食物被粪便污染,导致爆发大肠杆菌疫情[EB/OL]. 煎蛋网, [2018-12-09].
[5] 你所不知道的肠道菌群----中国科学院微生物研究所[EB/OL]. [2018-12-09].
[6] 中国营养学会. 中国居民膳食营养素参考摄入量(2013版)[M]. 科学出版社, 2014.
[7] DONDERO JR T J, RENDTORFF R C, MALLISON G F等. An outbreak of Legionnaires’ disease associated with a contaminated air-conditioning cooling tower[J]. New England Journal of Medicine, 1980, 302(7): 365–370.
[8] 罗世华. 一起 57 例 “空调病” 暴发的情况调查[J]. 解放军预防医学杂志, 2002, 20(4): 280–281.
[9] 裴晓旻, 裴红生, 黎新宇等. 北京市大饭店空调冷却塔军团菌污染现况及人群感染水?…[J]. 中华流行病学杂志, 2000, 21(4): 289–291
作者:赵言昌
